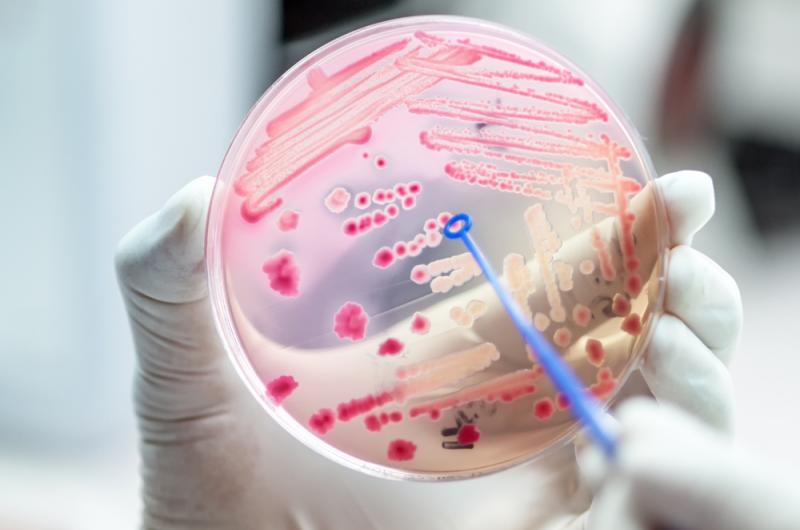

Digitale tentoonstelling over antibiotica en resistentie
Het digitale Nationale Farmaceutische Museum is uitgebreid met de tentoonstelling: ‘De erfenis van Fleming’ over antibiotica en resistentie. Hij werd gelanceerd op 3 september 2018, precies 90 jaar nadat Fleming per toeval het eerste antibioticum penicilline ontdekte.
Via deze link kun je terugblikken op het moment dat Alexander Fleming per toeval penicilline ontdekte. Hij kwam na een korte vakantie terug in zijn lab in het Londense St Mary Hospital waar hij een stel vergeten kweekschaaltjes ontdekte waarin hij verschillende bacteriën had laten groeien. Er groeide her en der ook wat schimmel. Tot zijn grote verbazing ontdekte hij echter dat de schimmel in één van de schaaltjes had gezorgd dat bacteriën stopten met groeien. Deze ‘schimmel’ bleek penicilline te zijn.
Speler van wereldformaat
Het was geneesmiddelenbedrijf Pfizer die de massaproductie ervan uiteindelijk in de jaren ’40 op zich nam. Hierdoor konden naar schatting vele honderdduizenden soldatenlevens worden gered tijdens de Tweede Wereldoorlog. Geïnfecteerde wonden die eerder leidden tot maandenlang herstel, amputaties of de dood konden nu opeens genezen. Na de oorlog startte een wereldwijde zoektocht naar nieuwe antibiotica.
De digitale expositie De erfenis van Fleming gaat ook in op de Nederlandse situatie: de verwoede pogingen van de Utrechtse hoogleraar Victor Koningsberger om nog tijdens de Tweede Wereldoorlog een antibioticum te ontwikkelen. Een fabriek bouwen bleek echter te duur en het patent ervoor bleek ook nog eens al te zijn vastgelegd door Amerikaanse en Britse fabrikanten.
Wel succesvol was de productie van penicilline door de Delftse Nederlandsche Gist- en Spiritusfabriek. Deze ontstond vlak na de Tweede Wereldoorlog. Tegenwoordig is DSM-Sinochem Pharmaceuticals - zoals het bedrijf nu heet - nog altijd een speler van wereldformaat qua penicillineproductie.
Schimmel versus bacterie
Een ander deel van de tentoonstelling vind je via deze link en draagt de titel Schimmel versus bacterie. Doel van deze expositie is uitleggen hoe je ziek kunt worden door bacteriën, virussen en andere parasieten. En waarom antibiotica werken bij bacteriële infecties, maar niet bij virussen. Ook krijg je een inkijkje in de precieze werking van antibiotica en de bacteriën of bacteriegroepen waar ze tegen worden ingezet.

Bij de behandeling van ernstige bacteriële infecties, zijn antibiotica noodzakelijk
Een gezond lichaam is in staat zelfstandig te herstellen van de meeste bacteriële infecties. Medicatie is dan niet nodig. Maar als de patiënt bijvoorbeeld niet genoeg weerstand heeft, kan de arts besluiten om een antibioticum voor te schrijven. Het antibioticum doodt een groot deel van de bacteriën of remt ze in hun groei, tot het lichaam weer voldoende weerstand heeft om zelf de resterende bacteriën uit te schakelen. Bij de behandeling van ernstige bacteriële infecties, zoals longontsteking, hersenvliesontsteking of bloedvergiftiging, zijn antibiotica echter noodzakelijk. Het lichaam is namelijk zelden in staat om daarvan op eigen kracht te herstellen.
Het gevaar van antibioticaresistentie
De digitale tentoonstelling De erfenis van Fleming besteedt ook aandacht aan de andere kant van de medaille: het gevaar van antibioticaresistentie.
Fleming waarschuwde in 1945 voor de keerzijde van antibioticagebruik
Het probleem van antibioticaresistentie is al zolang er penicilline bestaat bekend. Alexander Fleming waarschuwde in 1945 voor de keerzijde van antibioticagebruik.
Hij kreeg in dat jaar de nobelprijs voor de ontdekking van penicilline. Tijdens zijn toespraak waarschuwde hij voor het gevaar van antibioticaresistentie.
Er wordt uitgelegd hoe antibioticaresistentie ontstaat, wat dit voor een patiënt met een bacteriële infectie betekent en ook wordt stilgestaan bij de opkomst van multiresistente bacteriën.
Jaarlijks 48.000 doden
Nu overlijden er in Europa en de VS jaarlijks al 48.000 mensen door infecties die zijn veroorzaakt door multiresistente bacteriën. Deskundigen waarschuwen dat dit probleem in de toekomst alleen nog maar groter zal worden.
Wereldwijd slaan overheden, ziekenhuizen, geneesmiddelenbedrijven, veehouders en vele andere organisaties de handen ineen om antibioticaresistentie een halt toe te roepen.
In Nederland is de problematiek beperkt dankzij strenge preventieve hygiënemaatregelen in ziekenhuizen. En ook houdt de overheid met regelmaat campagnes om mensen ervan te vergewissen dat griep écht niet overgaat door antibioticagebruik.
Tot slot wordt in relatie daarmee nog even verwezen naar een reclamefolder van de Koninklijke Nederlandsche Gist- en Spiritusfabriek uit de jaren ’50. Toen werd al voorspeld dat gezamenlijke acties nodig zouden zijn in de strijd tegen antibioticaresistentie.
‘Wanneer u denkt, dat met de komst van penicilline de ziekten voorgoed op de vlucht zijn gejaagd, dan bent u verkeerd voorgelicht’, stond er geschreven. En ook: ‘als antibiotica te vaak worden gebruikt en onzorgvuldig worden ingenomen, kunnen steeds meer bacteriesoorten de werking van antibiotica weerstaan. Het is de gezamenlijke verantwoordelijk van artsen en patiënten om antibiotica optimaal te gebruiken: gebruik antibiotica goed en alleen als het moet.’
Bronnen
https://www.nationaalfarmaceutischmuseum.nl/exposities/erfenis-van-fleming